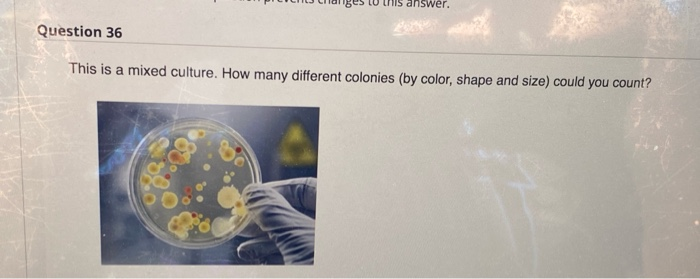
24. the answer is incorrect 27. the answer is

Question: 24. the answer is incorrect 27. the answer is incorrect. 32. the answer is incorrect 35. the answer is incorrect. 36. the answer is incorrect.
24. the answer is incorrect

27. the answer is incorrect.

32. the answer is incorrect


35. the answer is incorrect.

36. the answer is incorrect.

Step by Step Solution
There are 3 Steps involved in it
1 Expert Approved Answer
Step: 1 Unlock
Question Has Been Solved by an Expert!
Get step-by-step solutions from verified subject matter experts
Step: 2 Unlock
Step: 3 Unlock
